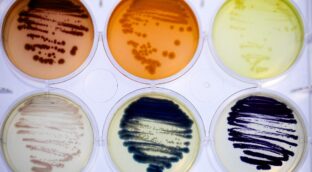
Colorifix posiciona los tintes biológicos como el futuro de la moda sostenible

LO MÁS LEÍDO AYER

Comenta las noticias de THE OBJECTIVE
Entra en la zona MyTO (en la barra superior, a la derecha) y crea gratis tu cuenta de usuario para poder comentar libremente todas las noticias del periódico. Además, podrás suscribirte a nuestras ‘newsletters’.
¡Suscríbete aquí!
MANAGEMENT

La newsletter de NieTO
Recibe cada mañana en tu correo electrónico una selección de las noticias más importantes elaborada por el director de THE OBJECTIVE, Álvaro Nieto.
Suscríbete aquí